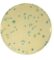

TBX Agar (BK146HA)
TBX Agar (BK146HA)
| Código Interno | Referência | Tamanho da Embalagem | |
|---|---|---|---|
| 1031700027 | 690230 | 500g | Fazer Cotação |
Informativos Técnicos
A Interlab disponibiliza o download dos informativos do produto TBX Agar (BK146HA), clique no link abaixo para visualizar as versões disponíveis para download.Buscar Informativos
Onde comprar
Nosso departamento de vendas possui duas equipes distintas: uma equipe treinada a atender as necessidades dos clientes da área clínica e a outra equipe para atender especificamente as indústrias.Cotação de Preços
A Interlab disponibilizou uma área onde você, interessado em nossos produtos, possa realizar uma cotação simples e rápida. Teremos prazer em atende-lo o mais breve possível.Fazer cotação